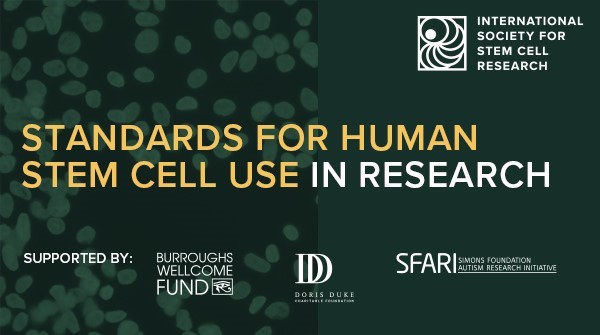
🎉🔬ISSCR releases new standards aimed at enhancing rigor and reproducibility in preclinical research &amp; ultimately strengthening the pipeline of therapies for patients. <a href="/stemcellreports/">StemCellReports</a> <a href="/BWFUND/">BWFUND</a> <a href="/DorisDukeFdn/">Doris Duke Foundation</a> @SFARIorg #ISSCRStandards

👉ow.ly/YTlq50OGaZo

JOYSON VERNER DCOSTA
@joysond
Islet you be stressfree, so you feel much beta. 🤭🤪
#TUD #CRTD #MPICBG
ID: 1077054449233866753
24-12-2018 04:12:46
195 Tweet
49 Followers
179 Following






In their new review, Max Planck Institute (Max Planck Institute for Medical Research) researchers Dr. Grapin-Botton, Seijo-Barandiaran, and Ho Lee explore the signaling molecules controlling morphogenesis in #organoids, and the mechanical cues controlling organoid shape 🔴 ⬜ 🔻. bit.ly/3DSHth1!


Stem cell based implants successfully secrete #insulin in patients with type 1 #diabetes. These phase I/II clinical trial data in Cell Stem Cell & Cell Reports Medicine are the first evidence of meal-regulated insulin secretion by differentiated stem cells in human patients. Papers below!🧵



Dr David Unwin 🥳great job!



🕰️ Time for a weekend review! #OrganOnAChip Scientists elaborate on different strategies to improve the vascularized human #BrainOrganoid microenvironment using #microfluidic devices. Full article in Lab on a Chip: 📖 rsc.li/43c8jx7


🎉🔬ISSCR releases new standards aimed at enhancing rigor and reproducibility in preclinical research & ultimately strengthening the pipeline of therapies for patients. StemCellReports BWFUND Doris Duke Foundation @SFARIorg #ISSCRStandards 👉ow.ly/YTlq50OGaZo

The first MPI-CBG Postdocs summer chalk talk took place today! It was a great turnout. The series will continue throughout summer.




Check out the beautiful work by Julien George Roth in Heilshorn Lab on construction of #assembloids by bioprinting Work supported by Stanford Brain Organogenesis Center in the Wu Tsai Neurosciences Institute & Stanford Bio-X nature.com/articles/s4146…


Together with the Cluster of Excellence Physics of Life (PoL) Physics of Life Dresden of the TU Dresden, the MPI-CBG Dresden is hiring a Postdoctoral Researcher in Pancreas Organoid Mechanics and Hydraulics. Apply here: mpi-cbg.de/join-us/open-p…



Researchers at Novo Nordisk Foundation including Dr. Anne Grapin-Botton integrated single-cell imaging and RNA sequencing datasets, linking differentiation and morphogenetic dynamics of human pancreatic #endocrine progenitors, with a particular focus on NEUROG3. bit.ly/3OKOJ53






